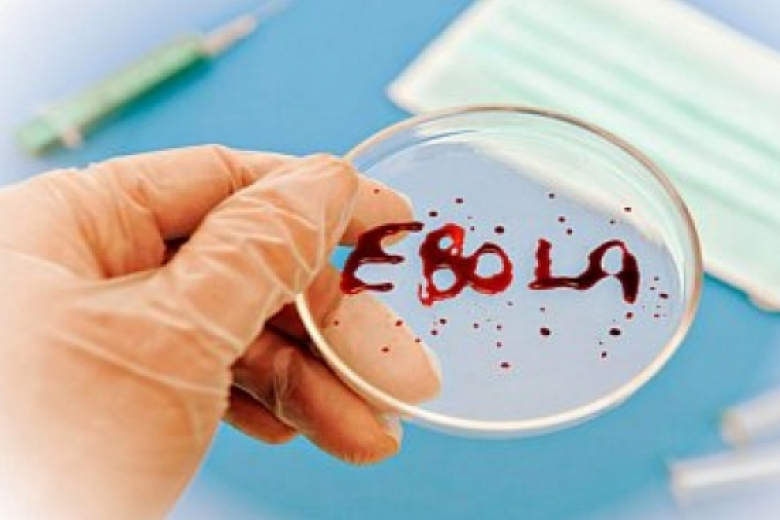

По данным Всемирной организации здравоохранения, официально инфицированными считаются еще 16 тыс. 169 человек
Число жертв лихорадки Эбола увеличилось до 6 тыс. 928 человек, инфицированы 16 тыс. 169 человек, сообщает Всемирная организация здравоохранения (ВОЗ).
Наибольшее количество пострадавших все так же приходится на три страны Западной Африки - Либерию (4 181 погибших, 7 244 зараженных), Сьерра-Леоне (1 463 погибших, 6 802 зараженных) и Гвинею (1 284 погибших, 2 123 зараженных).
Напомним, по данным на 23 ноября, сообщалось о 5 тыс. 689 погибших, 15 тыс. 935 заболевших.
Между тем генсек ООН Пан Ги Мун ранее заявлял, что в борьбе с распространением эпидемии наметился прогресс, но в ряде мест усилия властей по-прежнему "не поспевают за заболеваемостью".